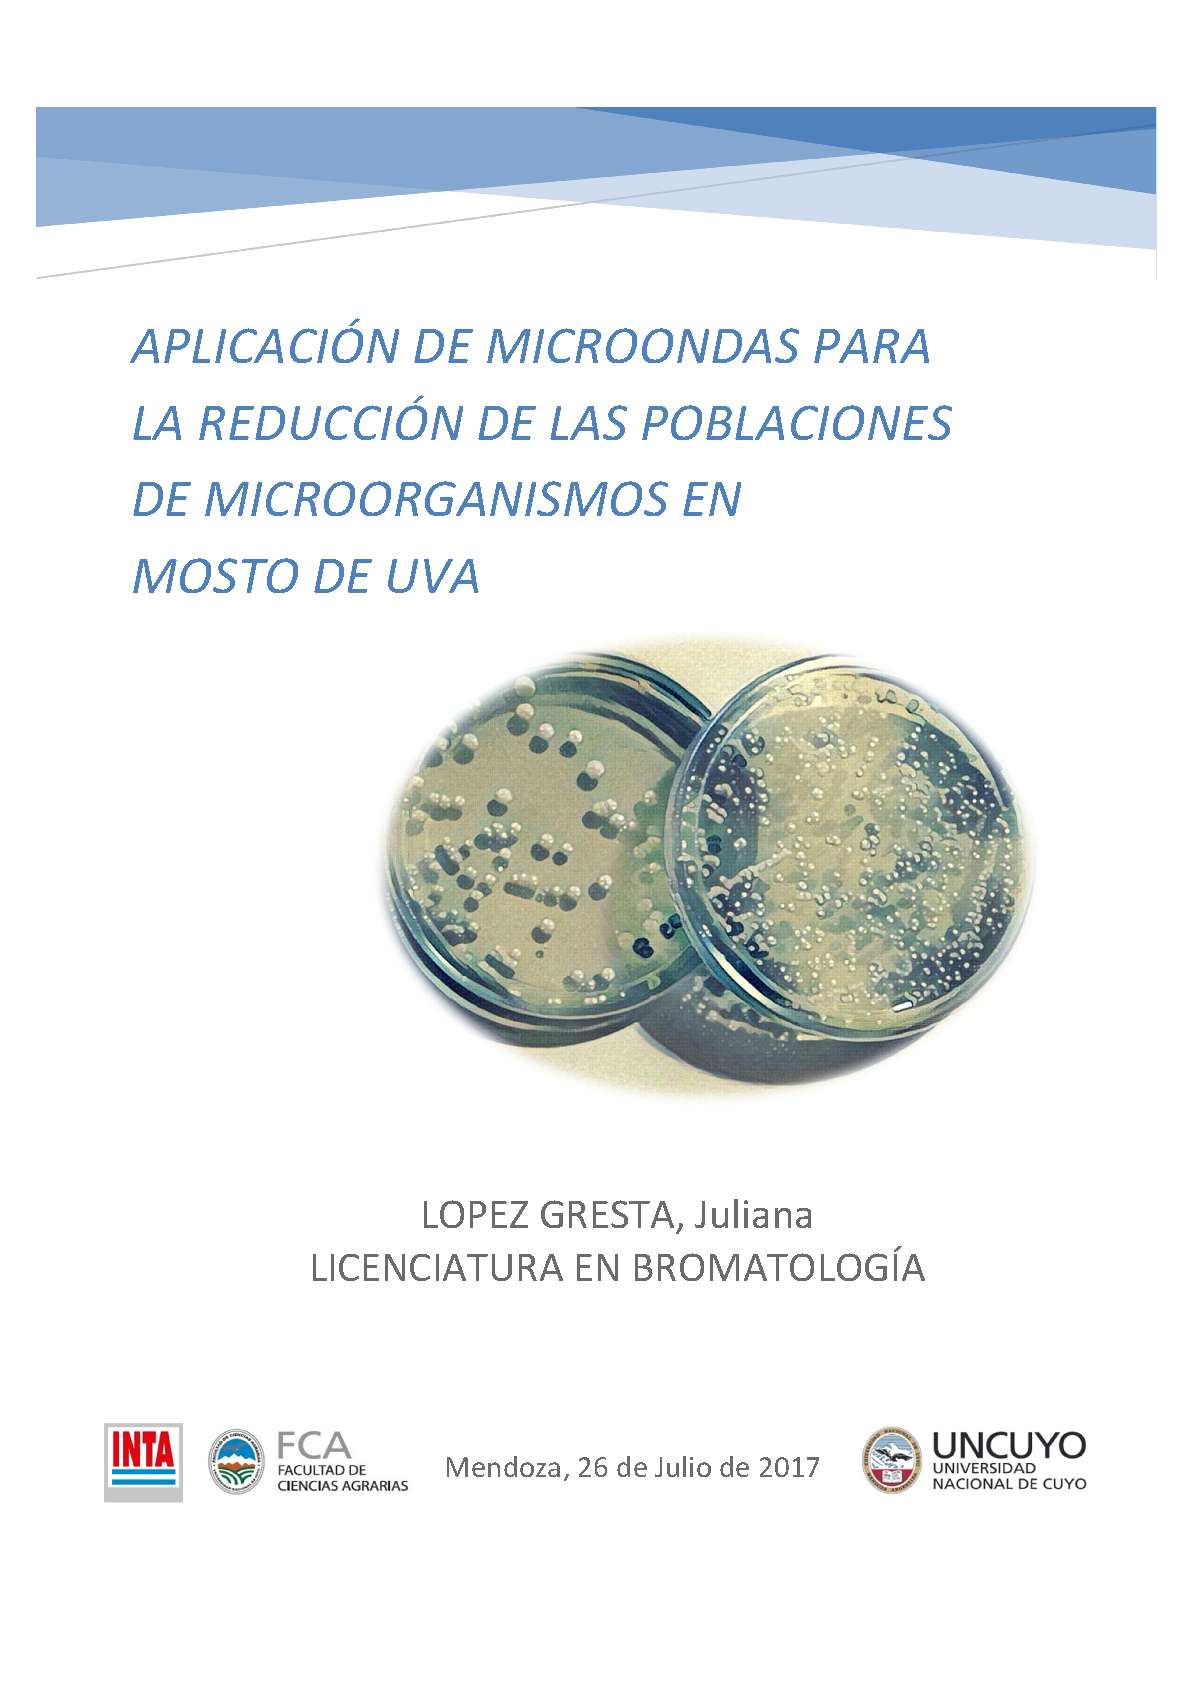

Identificador #9507·
Link permamente: /9507
 |
Tesina de grado |
|
 |
| |
Aplicación de microondas para la reducción de las poblaciones de microorganismos en mosto de uva
Por:
 Universidad Nacional de Cuyo. Facultad de Ciencias Agrarias
Universidad Nacional de Cuyo. Facultad de Ciencias Agrarias
Realizada en:
Páginas:
Idioma:
 |
|
Colaboradores:
Nombre de la carrera:
Institución:
Título al que opta:
La producción de vid y la elaboración de vino constituyen por excelencia dos actividades de
amplia tradición y gran impacto económico en Mendoza. Dos aspectos fundamentales para potenciar el desarrollo de dichas actividades son el aumento de la calidad en la producción de vinos y brindar un alimento seguro para el consumidor. Ambas perspectivas pueden abordarse desde una estrategia microbiológica, considerando que entre las levaduras y bacterias presentes en el mosto se encuentran las principales responsables de la fermentación alcohólica y maloláctica del vino, así como también microorganismos responsables del deterioro del mismo. El conocimiento y la comprensión de los fenómenos que determinan la presencia de distintas cepas de bacterias y levaduras constituyen una herramienta imprescindible para el abordaje de los desafíos actuales que plantea la producción de vinos a nivel mundial. En el presente estudio se propuso evaluar el uso de ondas electromagnéticas de alta frecuencia (microondas) como alternativa a emplear en la industria vitivinícola para disminuir la población microbiana en mosto, lo cual directamente permite disminuir la cantidad necesaria de SO2 a utilizar. Para ello, se evaluaron las poblaciones de Saccharomyces cerevisiae, Hanseniaspora uvarum, Pichia membranaefaciens, Zygosaccharomyces rouxii, Dekkera bruxellensis,
Lactobacillus spp y Acetobacter spp inoculadas en mosto de uva antes y después del
tratamiento en microondas a una potencia de 250 watts, durante 2,3 y 4 minutos. Se pudo
verificar que S. cerevisiae y Lactobacillus spp. fueron los microorganismos que mostraron
mayor resistencia al tratamiento de microondas, por otro lado D. bruxellensis y H. uvarum,
fueron los microorganismos más sensibles. La información generada demuestra que la
reducción de las poblaciones microbianas de mostos de uva mediante tratamiento con
microondas dependió del microorganismo que se trata.
Disciplinas:
Ciencia y tecnología de los Alimentos
Descriptores:
MOSTO DE UVA - MICROORGANISMOS - DIÓXIDO DE AZUFRE - TRATAMIENTO POR MICROONDAS - MENDOZA (ARGENTINA : PROVINCIA)
Palabras clave:
Población microbiana - Anhídrido sulfuroso

Este obra está bajo una Licencia Creative Commons Atribución-NoComercial-CompartirIgual 3.0 Unported.
Conozca más sobre esta licencia >
|
|
 |
|
 |
|

|
|
Fichas descriptivas de las especies del jardín botánico en la Fac. de Ciencias Agrarias.
Selección de trabajos alrededor de la temática de los Derechos Humanos en la Argentina y en Mendoza en particular.
Una selección de artículos, tesis, informes de investigación y videos sobre temáticas de la vid, la vinificación, la economía y la cultura del vino mendocino
Espacio virtual que pone a disposición tesis doctorales y trabajos finales de maestría de posgrados dictados en la Facultad de Filosofía y Letras de la UNCuyo.
En este sitio se pueden consultar las tesis de grado de la Facultad de Cs. Económicas de la UCuyo. La búsqueda se puede hacer por autor, titulo y descriptores a texto completo en formato pdf.

|
| //DOSSIERS ESPECIALES |
|
Cada Dossier contiene una selección de objetos digitales en diversos formatos, bajo un concepto temático transversal.
La propuesta invita al usuario a vincular contenidos y conocer los trabajos que la UNCuyo produce sobre temáticas específicas.
|
| |
| Para la correcta utilización de todos los materiales de esta biblioteca es necesario que disponga de: |
 |
 |
|




